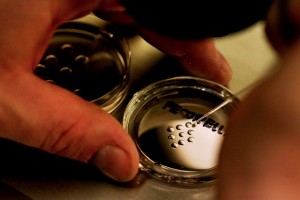

¿Qué es la medicina regenerativa?
Hace algunas décadas la idea de poder crear órganos era más propia de un filme de ciencia ficción que de la realidad, al igual que la regeneración de tejidos que han sido dañados debido a un traumatismo o por el paso de los años. Sin embargo, hoy estamos más cerca de lograr estas cosas, gracias a la medicina regenerativa, una rama que cohesiona diferentes áreas científicas, como la ingeniería genética y la terapia celular.
Hace algunas décadas la idea de poder crear órganos era más propia de un filme de ciencia ficción que de la realidad, al igual que la regeneración de tejidos que han sido dañados debido a un traumatismo o por el paso de los años. Sin embargo, hoy estamos más cerca de lograr estas cosas, gracias a la medicina regenerativa, una rama que cohesiona diferentes áreas científicas, como la ingeniería genética y la terapia celular.
Básicamente, la terapia celular recurre a las células madre o a determinadas células especializadas para poder crear diferentes tejidos. Así se logra generar un tejido sano que irá a reemplazar el tejido lesionado. Las personas que necesitan un trasplante de médula ósea han sido las que más se han beneficiado con este avance ya que en la actualidad se logra sustituir con un buen porcentaje de éxito las células enfermas (leucemia) con células sanas.
Por supuesto, los investigadores no se han detenido en las células hematopoyéticas sino que han ido un paso más allá para comenzar a trabajar con células madre embrionarias, a partir de las cuales es posible obtener diferentes tejidos, como neuronas o hueso.
Por otra parte encontramos la ingeniería genética, que consiste en insertar un gen en una célula para intentar substituir o bloquear la acción de un gen defectuoso. Como podrás suponer, estas técnicas se suelen usar para tratar enfermedades de origen hereditario.
No obstante, uno de los pilares de la medicina regenerativa es la ingeniería de tejidos; o sea, la construcción de órganos en un laboratorio para reemplazar a los que han dejado de funcionar o lo hacen de manera defectuosa. Para fabricar estos órganos se utilizan diferentes materiales, desde células vivas hasta sustancias poliméricas. Actualmente se han logrado desarrollar uretras, vejigas, una tráquea o una oreja.
Obviamente, estos no son sino los primeros pasos de una rama de la medicina que surgió en los años ’60. Aún queda mucho camino por andar y es probable que en un futuro esta sea la respuesta a muchas enfermedades graves que hoy nos azotan, como el Alzheimer o el cáncer.
Imagen del artículo
